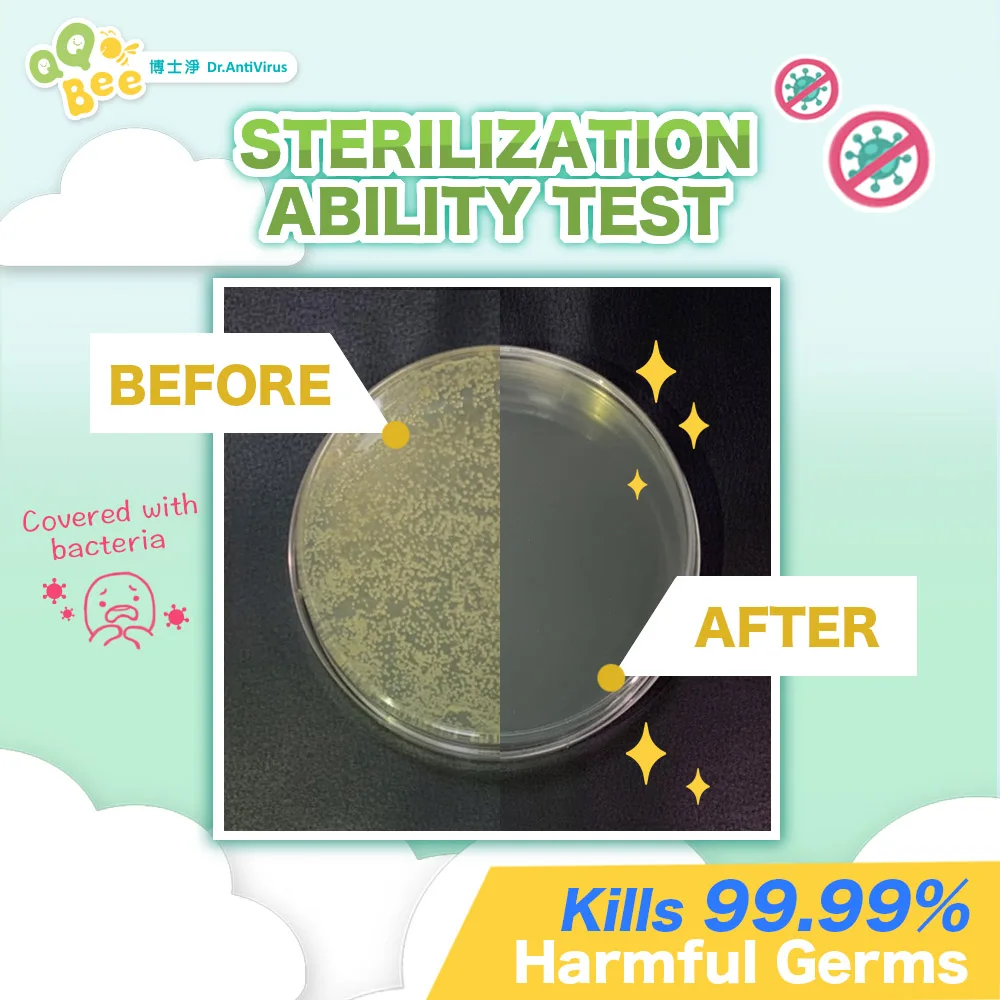

Pet Hair Lint Washing Ball For Cat Dog Pet Fur Remover
US $0.10-$0.55
Share on (10000004902911):


HS CODE | SIZE | PACKING (PER BOX) | BOX SIZE | BOTTLE TYPE |
34029000009 | 1000ML | 12 Bottle Per Box | 36 CM *27 CM * 52 CM | HDPE |

New products from manufacturers at wholesale prices